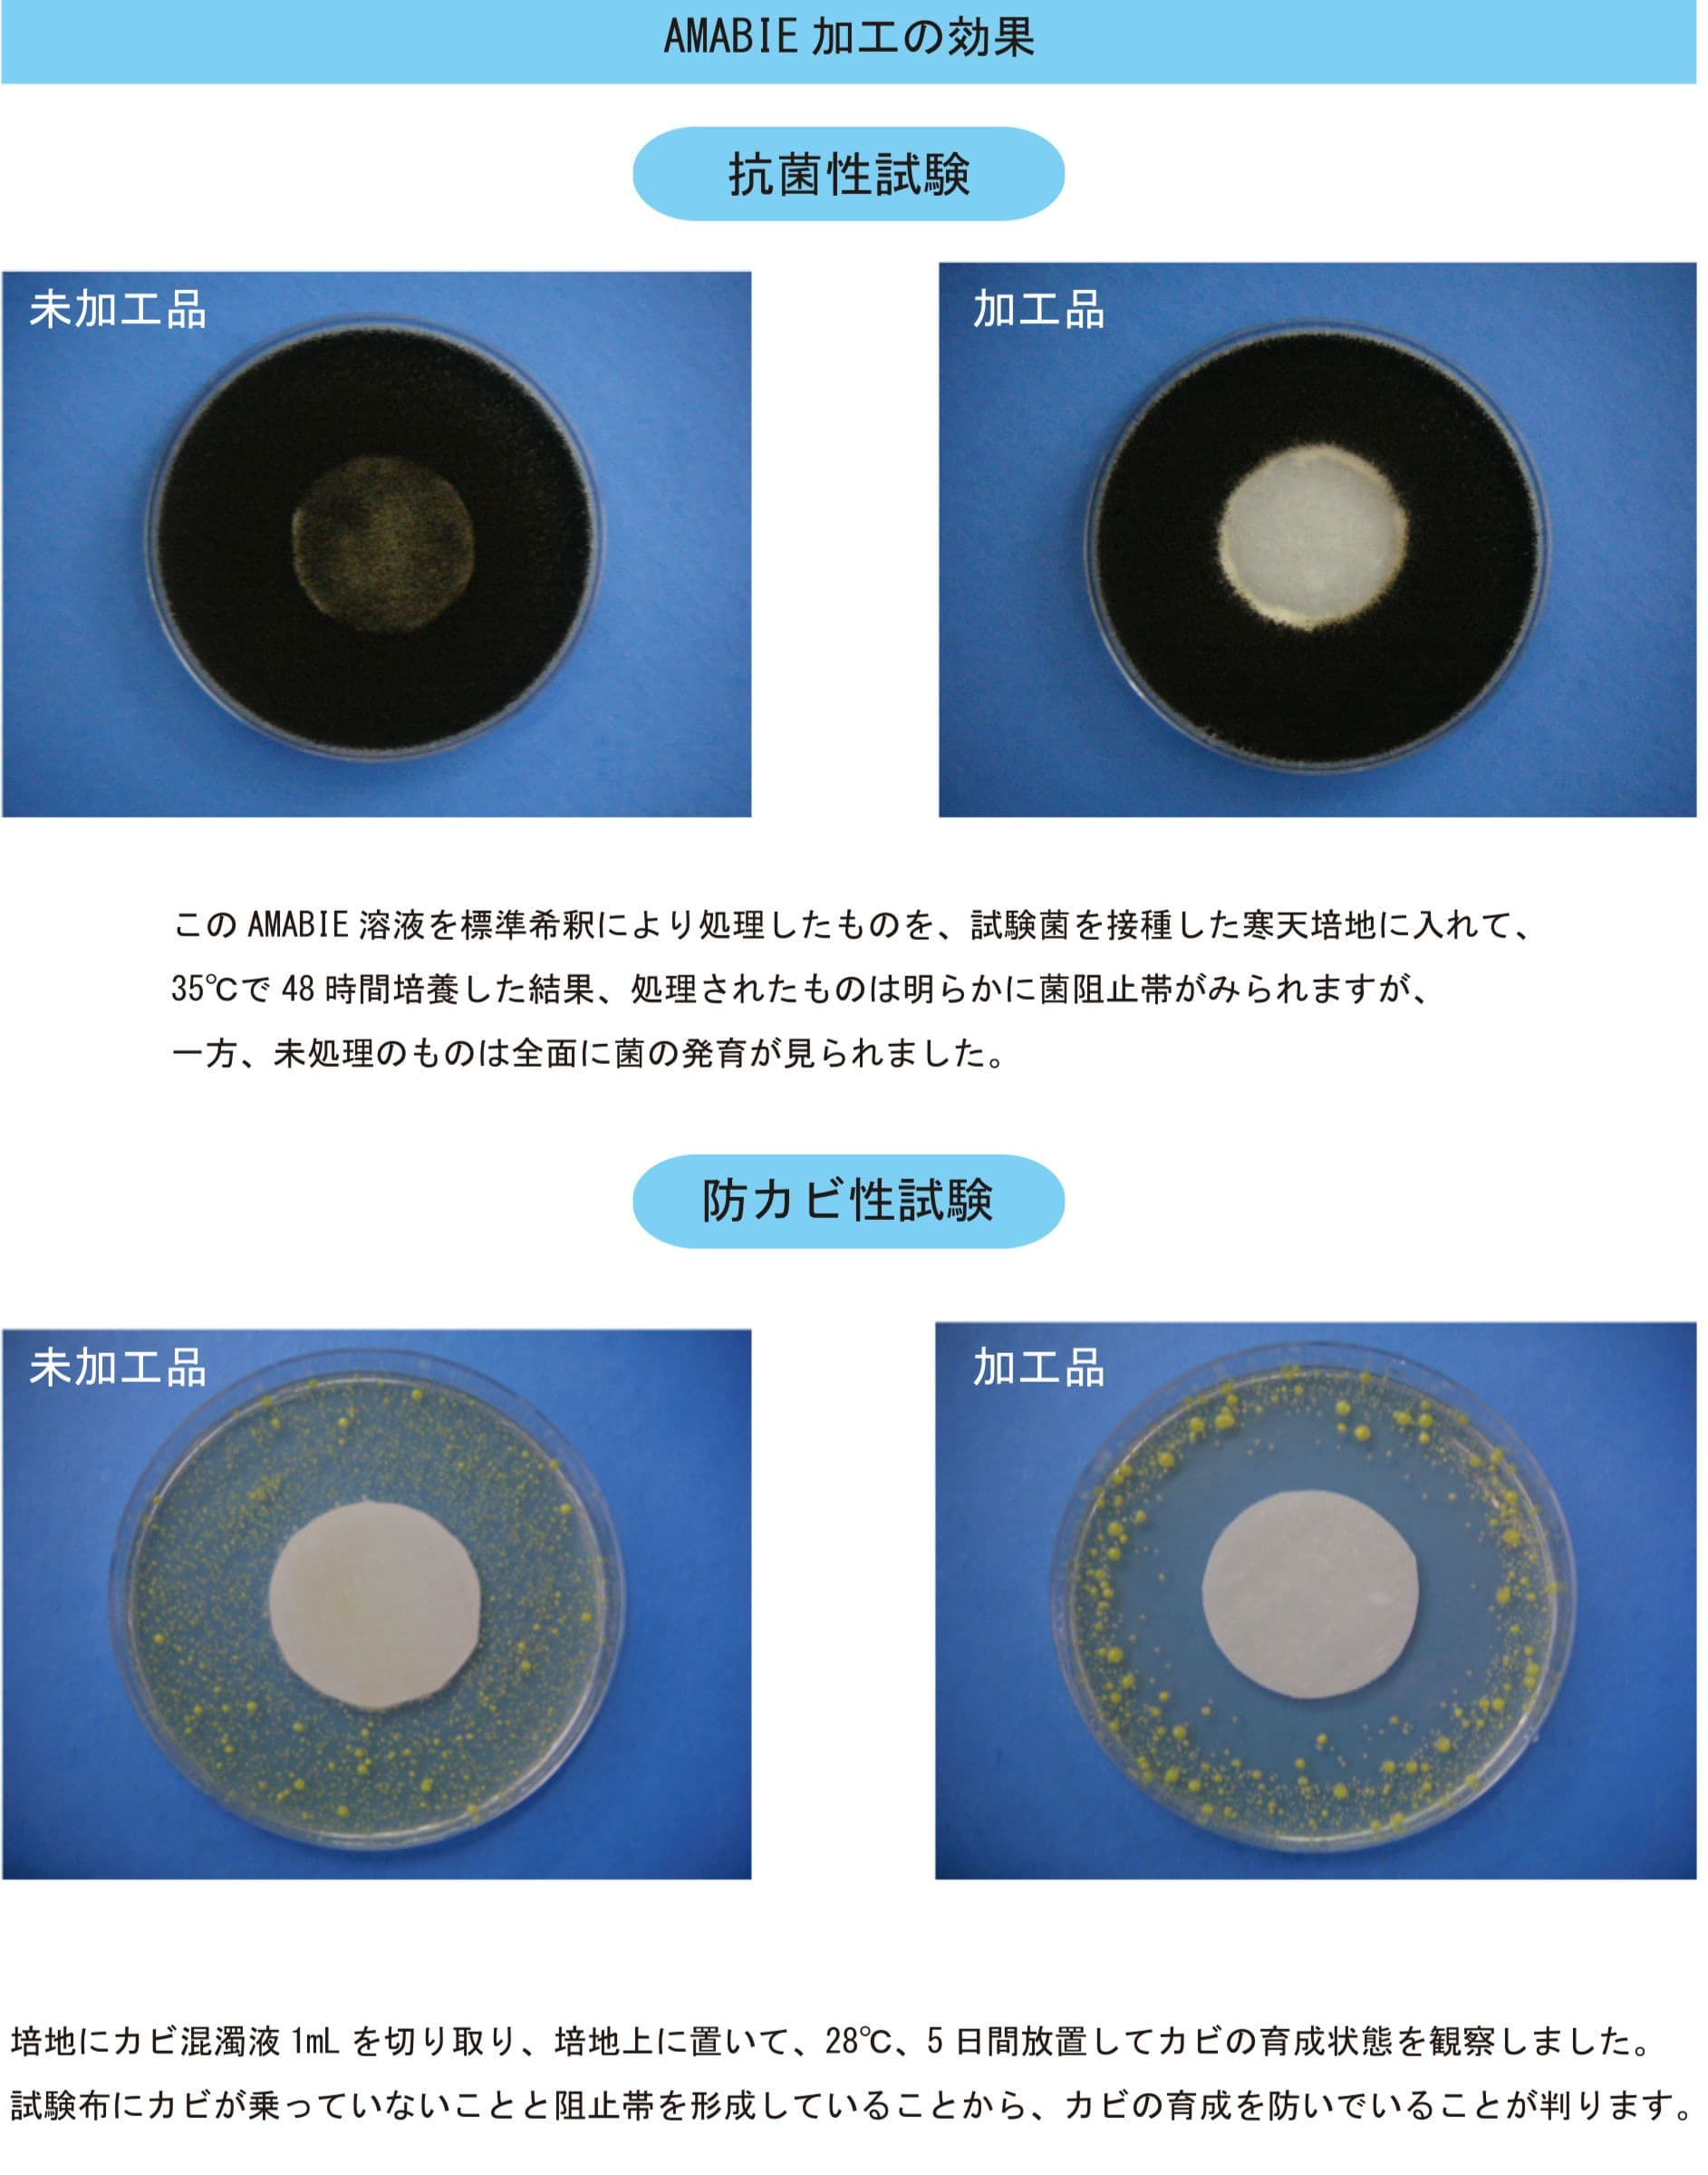

Amabie剤とは
イオン性界面活性剤の中のカチオン界面活性剤
竹村株式会社で薬品会社協力のもと、「Amabie」というクリーニングでも使用可能な除菌剤で
コロナウイルスに有効と判断された成分を加え抗ウイルス、抗菌、防カビ、消臭剤として企画。
Amabie剤の主成分である塩化ベンサルコニウムは、新型コロナウイルスを実際に使用した
確認方法により、同ウイルスの粒子数を0.05%で2分間処理により99.999%、また0.01% 5分間処理により99.99%減少させる効果があることが実証されております(JIS規格L1922)によると、
減少率99%以上で「効果あり」、99.9%以上で「十分に効果あり」と評価されます。
この液体は界面活性剤でもあり、イオン性界面活性剤の中のカチオン界面活性剤という位置付けになります。
※消臭加工とは:汗や雑菌から発生した不快なニオイを軽減する効果のある加工です。
カチオン界面活性剤
水に溶けたとき、陽イオンになる界面活性剤で石けんとイオン的に逆の構造をもっているため「逆性石けん」と呼ばれることもあります。
繊維やウールなどのマイナス(負)に帯電している固体表面に強く吸着し、殺菌性などを付与することができます。構造的にはアミン塩型と第4級アンモニウム塩型に分類され、繊維の柔軟剤、へアリンス基剤や殺菌剤として第4級アンモニウム塩型が広く使用されています。

注意事項
Amabieは塩化ベンザルコニュウム配合により
エンベロープを有するウイルスに
有望であると同時に、
多くの菌に対して有効で、
持続性も認められますが、
新型コ
ロナ感染予防効果を保証するものではありません。
新型コロナウイルスに対する予防効果を標某する商品等の表示に関する改善要請等及び一般消費者等への注意換気について(第3報)
消費者庁HP https://www.caa.go.jp/notice/entry/020124/